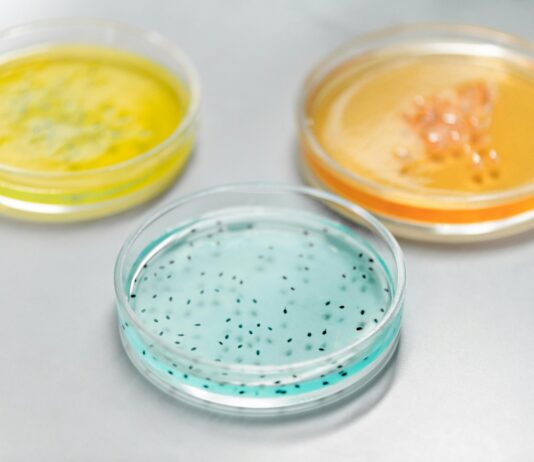
Clinical Pathology Laboratories: Unlocking Secrets Behind Accurate Diagnoses

Dental Implants Hungary Helvetic Clinics: Why Choose Them?
Are you tired of struggling with missing teeth and looking for the best solution abroad? Discover the amazing world of dental implants Hungary Helvetic...
Emergency Dental Clinic Near Me: How To Find Fast, Reliable Care
Are you currently facing a sudden toothache or dental trauma and desperately searching for an emergency dental clinic near me? You’re not alone! Many...
Cornerstone Veterinary Clinic: Why Choose Us For Your Pet’s Care?
When it comes to finding the best veterinary care for your beloved pet, making the right choice can feel overwhelming. Cornerstone Veterinary Clinic stands...
Everett Clinic Secrets Revealed: Why Patients Trust Their Care
Everett Clinic Secrets Revealed: Why Patients Trust Their Care is the ultimate guide to understanding what sets this healthcare provider apart in a crowded...
Emergency Clinics Near Me: Discover The Best Care When It Matters Most
When unexpected health issues strike, finding emergency clinics near me becomes an absolute priority. But how do you discover the best care when it...
Std Clinic Near Me: Discover Trusted Care and Confidential Testing
Are you searching for the best STD clinic near me but feeling confused about where to go? Finding a reliable and confidential sexual health...
Free Dental Clinic: Discover How To Access Top Care Without Cost
Are you struggling to find quality dental care without breaking the bank? Free dental clinic services could be the lifesaver you’ve been searching for!...
Community Clinics Near Me: Discover Trusted Local Healthcare Options
Are you searching for community clinics near me to get affordable and reliable healthcare services close to home? Finding trusted local healthcare options can...
Primary Care Clinic: Discover Essential Benefits For Your Health Today
Are you curious about how a primary care clinic can transform your overall well-being? In today’s fast-paced world, discovering the essential benefits of having...
Albion Clinic Glasgow: Discover Expert Care and Trusted Treatments
Are you searching for the best Albion Clinic Glasgow experience that promises outstanding results and personalized care? Look no further because this clinic has...
Clinical Practice Guidelines: Essential Insights Every Clinician Needs
Clinical Practice Guidelines: Essential Insights Every Clinician Needs is a must-read article for healthcare professionals eager to elevate their patient care game. Are you...
Ogden Clinic Patient Portal: Discover Easy Access To Your Health Records
Unlocking seamless healthcare management has never been easier with the Ogden Clinic Patient Portal, your ultimate gateway to easy access to your health records...
When to Visit a Retail Clinic Inside Your Local Pharmacy
This article explores the ins and outs of retail clinics in pharmacies, including when to go, what to expect, and why you might wanna...
Sex Clinic Near Me: Discover Expert Care and Confidential Services
Looking for a reliable sex clinic near me can be overwhelming, isn't it? Many people feel shy or unsure where to start when it...
Medical Clinic Near Me: How To Find Trusted Care Quickly
Searching for a medical clinic near me can sometimes feel overwhelming, especially when you need trusted care quickly. Whether you're dealing with a sudden...
Clinical Partners Autism Test: How Accurate Is It Really?
When it comes to understanding autism spectrum disorder (ASD), parents and caregivers often face a crucial question: Clinical Partners Autism Test: How Accurate Is...
London Womens Clinic Secrets: Why It’s The Best Choice For You
Are you searching for the best London women’s clinic that truly understands your unique health needs? Look no further, because in the heart of...
Emergency Clinic Near Me: How to Find Fast, Reliable Care Today
Are you frantically searching for an emergency clinic near me but not sure where to turn? Finding the right urgent care center in your...
Belgravia Clinic Secrets: How They Transform Hair Loss Effectively
Are you searching for the ultimate destination to transform your look and boost your confidence? Look no further than the Belgravia Clinic, a top...
Animal Medical Clinic Secrets: How To Keep Pets Healthy Naturally
Unlock the hidden world of Animal Medical Clinic Secrets and discover how to keep pets healthy naturally like never before! Ever wondered what top...
Watson Clinic Patient Portal: Unlock Powerful Benefits Today
Are you tired of waiting on hold or struggling to get your medical records? The Watson Clinic Patient Portal is here to revolutionize the...
NHS Gum Clinic: How Can It Transform Your Oral Health Today?
Are you looking for the best NHS gum clinic near you that offers affordable and effective treatments? Finding the right place for your gum...
Affordable Pet Clinic: Discover How To Save Big On Quality Care
Are you tired of spending a fortune on pet healthcare? Finding an affordable pet clinic that provides top-notch care without breaking the bank can...
Va Medical Clinic Near Me: Discover Expert Care and Trusted Support
Are you searching for a VA Medical Clinic Near Me that offers expert care and trusted support for veterans? Finding the right healthcare provider...
Fortius Clinic Secrets Revealed: Why Patients Choose Their Care
Are you looking for the best place to transform your health and wellness journey? Look no further than Fortius Clinic, a leading destination for...